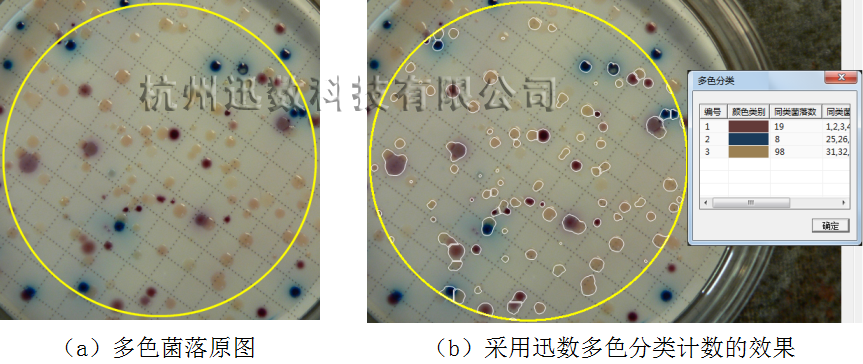

多色菌落,是微生物檢測中常常遇到的現(xiàn)象。不同顏色的菌落往往代表不同的細(xì)菌,對多色菌落的分類檢測也就成為一項重要的工作。目前,對多色菌落的自動分類一般采用彩色立方體的方法來進(jìn)行。這種方法操作簡單,但效果往往不好。這是因為:
(1)屬于同一種顏色的各個菌落,其表面顏色并非完全一樣,有時還往往存在相當(dāng)大的差異。比如下圖1-a、1-b中,紅色菌落有深紅色和淺紅色,但顯然它們屬于同一類;下圖1-c中,二個紅色菌落顏色深淺不一樣,而且表面還有反光引起的色斑。
(2)對單個菌落來說,其表面顏色也不是一成不變,往往中間部分顏色較深,而其他部位顏色略淺,周圍甚至還有因擴散而引起的更淺的一圈顏色,如下圖1-a中的藍(lán)色菌落。
由于以上原因,傳統(tǒng)的彩色立方體等方法往往將一個完整的菌落分割成許多碎片,圖2顯示了采用這種方法對圖1分割的局部放大,藍(lán)色菌落的色素擴散導(dǎo)致一個菌落被過分割成內(nèi)圈和外圈兩部分。
而另一方面,基于水平集活動輪廓模型的圖像分割方法,具有抗噪性強、數(shù)值求解穩(wěn)定性好、分割邊界光滑連續(xù)等優(yōu)點,不會造成過分割、或分割出許多碎片的現(xiàn)象。如何將顏色作為約束條件引入水平集活動輪廓模型,來解決上述多色菌落的自動分類,是迅數(shù)科技研發(fā)團(tuán)隊近年來攻關(guān)的目標(biāo)之一,目前已取得成功,能良好解決多色菌落的自動分類問題。
1、基于RGB約束的水平集活動輪廓模型多色聚類
水平集活動輪廓模型的基本原理,是把曲線或曲面嵌入高一維水平集函數(shù)中,用一個高維函數(shù)來表達(dá)低維曲線或曲面的演化過程。建立具有閉合曲線長度和面積平滑約束項的二維能量泛函(即CV模型):

上式中,I(x,y)是圖像中各象素點的灰度、co和cb分別是菌落輪廓線內(nèi)部和外部的平均灰度值。上式的前兩項用于控制菌落輪廓曲線的光滑性,后兩項驅(qū)動該輪廓線向?qū)嶋H菌落輪廓收縮,極小化該能量泛函即完成對菌落圖像的分隔。
傳統(tǒng)的CV模型只利用灰度信息,對色彩信息豐富的多色菌落分割效率低。為了將彩色信息融入其中,把傳統(tǒng)的基于灰度信息的梯度指示函數(shù)改為基于彩色信息的梯度指示函數(shù)。設(shè)I(x,y)表示彩色圖像在點(x,y)處的三個R、G、B向量。定義E、F、G和fcolor如下:

Ecv(Ф) 的能量函數(shù)表達(dá)式為:

其梯度下降流如下:

其中I、c1、c2分別是圖像灰度值、輪廓線內(nèi)外的平均灰度值。為將彩色信息加入,把傳統(tǒng)的灰度差值改為R、G、B三通道的差值加權(quán)平均。表達(dá)式如下:

其中c1i和c2i是輪廓線內(nèi)外三個通道的平均值,Ii對應(yīng)三個通道強度值。綜合基于梯度和基于CV模型的彩色活動輪廓模型的曲線演化方程如下:

上述基于彩色梯度與多通道CV模型的綜合活動輪廓模型,可以較好的解決多色菌落圖像的顏色自動分類問題。
2、多色菌落的自動分類試驗
圖3、4分別顯示了對多色菌落采用迅數(shù)多色分類技術(shù)所分割的效果。
圖3顯示了對3種顏色菌落的自動分類檢測。首先,從菌落圖像(圖3-a)獲取紅、藍(lán)、黃三種菌落的先驗知識,通過RGB模型將其加入CV水平集活動輪廓模型的約束條件中。這樣,CV模型的演化過程中,僅對規(guī)定的顏色輪廓進(jìn)行收縮,分類結(jié)果如圖3-b所示。
圖3多色菌落的自動分類效果
圖4顯示了對包含2種顏色菌落、但具有明顯色素擴散的多色菌落的自動分類。其方法同上,先從菌落圖像(圖4-a)獲取紅、綠二種菌落的先驗知識,通過RGB模型將其加入CV水平集活動輪廓模型的約束條件中。這樣,CV模型的演化過程中,僅對規(guī)定的顏色輪廓進(jìn)行收縮,分類結(jié)果如圖4-b所示。

圖4多色菌落的自動分類效果
3、總結(jié)
基于水平集活動輪廓模型的圖像分割方法,具有抗噪性強、數(shù)值求解穩(wěn)定性好、分割邊界光滑連續(xù)、可以處理拓?fù)浣Y(jié)構(gòu)復(fù)雜的情況等優(yōu)點,能夠解決許多復(fù)雜的問題。
迅數(shù)科技研發(fā)團(tuán)隊,歷經(jīng)兩年多的攻關(guān),不僅掌握了這一先進(jìn)技術(shù),而且針對微生物菌落的特點,在傳統(tǒng)的水平集活動輪廓模型的基礎(chǔ)上,通過引入各種約束機制與邊界條件,創(chuàng)造性的研究開發(fā)出適合多種復(fù)雜情況的先進(jìn)的圖像分割或自動分類技術(shù),為菌落計數(shù)、顯微圖像分析等提供了實用和先進(jìn)的技術(shù)。